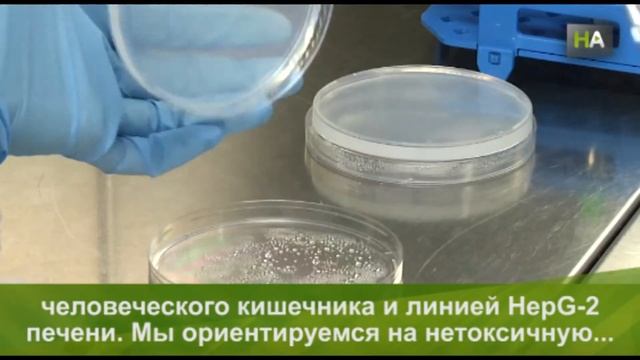
НА Пластик с добавлением глины. Новые упаковки для мяса продлевают срок годности продукта смотреть онлайн

Автор / Канал: Уборка с вниманием к деталям Страница 9

Полевой тест NIUDADA: фильтр для воды с AliExpress

Обзор кулер (диспансер) для воды ECOCENTER H-X53E

Amazoncom Bioderma Sensibio H2O Soothing Micellar Cleansing Water and Makeup Removing Solution for

重新追妻?校草前男友可怜巴巴求原谅,女主心软却没立刻答应 | clip 初恋那件小事 A Little Thing Called First Love
НА Пластик с добавлением глины. Новые упаковки для мяса продлевают срок годности продукта

"Простая" Лихорадка
![Купили яхту за $1000! Vindö 22 [S1E2] смотреть онлайн Купили яхту за $1000! Vindö 22 [S1E2] смотреть онлайн](https://pic.rtbcdn.ru/video/89/27/8927d19735ca415f5f6a4f30a0b4ba99.jpg)
Купили яхту за $1000! Vindö 22 [S1E2]

Урок номер 2 "Как вязать круг"

mmc L200 Замена пыльника ШРУС

Ваз 2114 замена прокладка под ГБЦ для глухих

Новое поступление Японских тракторов на склад в Краснодар.

кошелек 2 001

Эмоциональный КОМПАС

Быстрый способ почистить кальмары. Теперь чищу только так!

Jansite зеркальный автомобильный видеорегистратор T67S с 4 k разрешением, 2-мя камерами и GPS

Прощай чугунная ванна. Goodbye Cast Iron Bath.

замена мембраны квкг, замена прокладки крышки головки блока цилиндров на двигателе n13b16 BMW

Laravel YouTube API клон #79 - Удаление аккаунта вместе с комментариями и API токенами

04 - Start Ups com Impacto | Pitch 3 | Marina Banazol

Яндекс ТВ Станция Про

Xiaomi Redmi 9 обзор глобальная версия смартфона

Елизавета Петренко - А.Блок "Россия"
За каждым успешным каналом стоит личность, идея и сотни часов кропотливого труда. Если вы здесь, значит, автор «Уборка с вниманием к деталям» уже сумел зацепить ваше внимание своим уникальным стилем или подачей. А мы на RUVIDEO позаботились о том, чтобы вы могли изучить весь архив его работ в максимально комфортных условиях — без лишней суеты и преград.
Почему за работами канала «Уборка с вниманием к деталям» так интересно наблюдать? Всё просто: это честный контент, который находит отклик в сердцах зрителей. На нашем ресурсе вы можете смотреть онлайн все видео любимого автора бесплатно и в хорошем качестве. Нам важно, чтобы вы видели каждую деталь и слышали каждый нюанс, поэтому мы используем только стабильные плееры из открытых источников Rutube.
Следите за новинками канала, пересматривайте старые шедевры и открывайте для себя новые грани творчества «Уборка с вниманием к деталям». Мы постоянно обновляем ленту, чтобы у вас под рукой всегда были самые свежие выпуски. Никаких сложных регистраций — только вы и творчество, которое вдохновляет. Приятного вам путешествия по миру авторского контента на RUVIDEO!
Видео взято из открытых источников Rutube. Если вы правообладатель, обратитесь к первоисточнику.